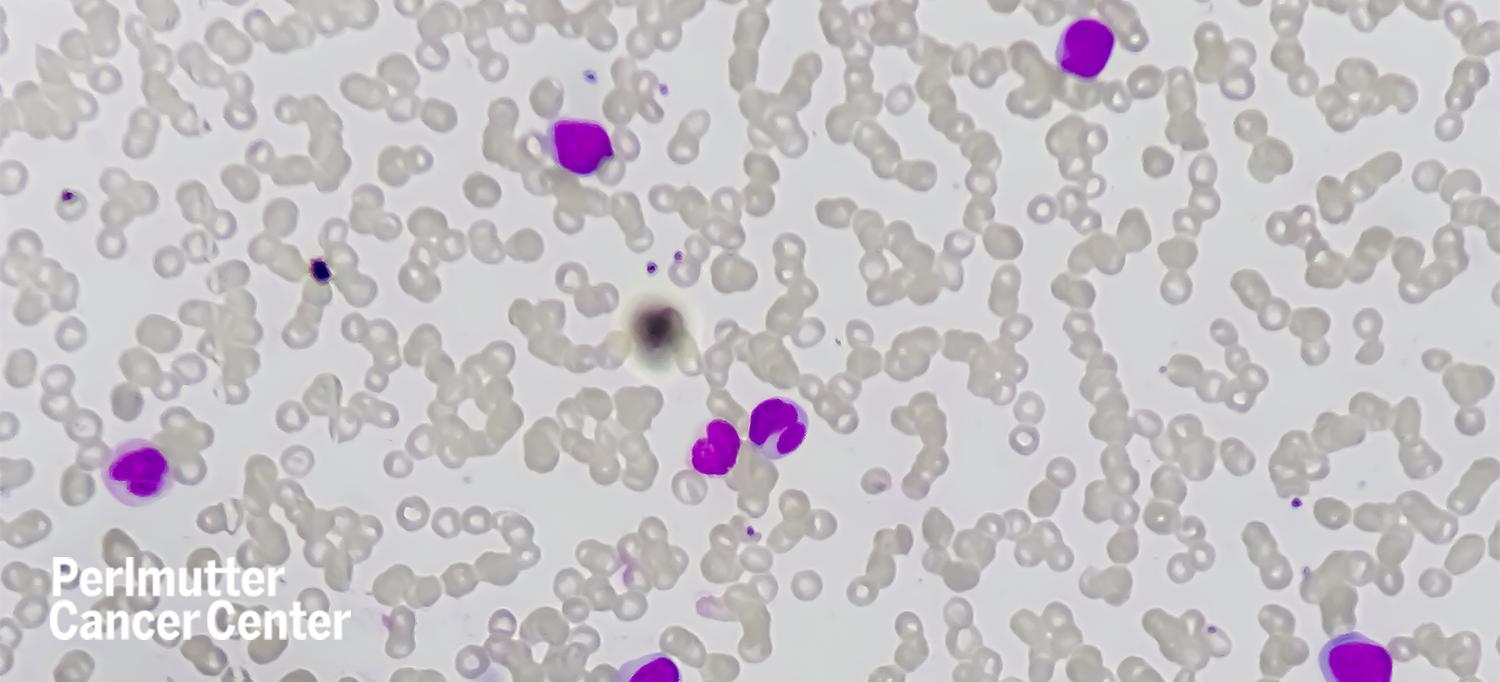

Photo: Md Ariful Islam/Getty
Treatment for people with acute myeloid leukemia (AML) sometimes includes an allogeneic hematopoietic stem cell transplant. At the 2022 annual meeting of the American Society of Hematology, researchers presented data from a phase 3 clinical trial showing that using intensive chemotherapy to achieve remission does not provide a benefit over watchful waiting and sequential conditioning before providing an allogeneic hematopoietic stem cell transplant.
Mohammad Maher Abdul Hay, MD, director of the Clinical Leukemia Program at NYU Langone Health’s Perlmutter Cancer Center, discusses the study with Cancer Therapy Advisor.
“The only counterargument for this study is that the reinduction regimen used also contained high-dose cytarabine and anthracycline for patients who already failed cytarabine and an anthracycline, and we can’t help but wonder if targeted therapies or introducing other reinduction regimens like FLAG [fludarabine, cytarabine, and granulocyte colony stimulating factor] would have made a difference,” says Dr. Abdul Hay, who is also an associate professor in the Department of Medicine at NYU Grossman School of Medicine.
Read more from Cancer Therapy Advisor.

